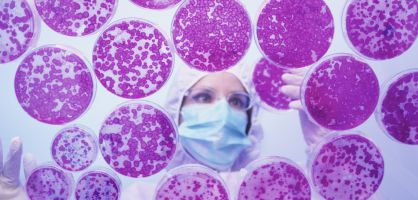

Última hora
La alcaldesa de Madrid, arropada por Sáenz de Santamaría y Gallardón, sostiene que la carrera olímpica "ya ha proporcionado a la ciudad todos los beneficios que podemos esperar de ella"
El secretario de Estado para el Deporte, Miguel Cardenal, fue uno de los más escépticos sobre la posible victoria de la candidatura
Una inmensa cadena humana cruza Cataluña de norte a sur. Los convocantes exigen a Mas y Rajoy un referéndum en 2014. El Gobierno de CiU insiste: "El PP no puede quedarse sentado"
Un grupo ultraderechista irrumpió en el acto a voces de "Cataluña es España" y dejaron cinco heridos leves
La Asamblea Nacional Catalana logra su objetivo de que una cadena humana cruce Cataluña de punta a punta
En una carta en ‘The New York Times’, el presidente ruso dice a los estadounidenses que un ataque a Siria traerá más terrorismo en un conflicto con "pocos campeones de la democracia"
Tras el ataque con gas tóxico de agosto, esta zona ofrece una visión fantasmal: casas intactas, pero sin moradores
Según 'The Washington Post', comenzaron a llegar hace dos semanas. El departamento de Estado envía ayuda no letal
Las operadoras no podrán cobrar por recibir llamadas dentro de la UE en julio de 2014 y el 'roaming' debería desaparecer en 2016
El Gobierno, que había rebajado un 22% la dotación a seis hospitales, deberá modificar los presupuestos por segundo año
La reforma municipal inicia su trámite parlamentario con la oposición de los municipios
Moscú ha paralizado todos los procesos de ciudadanos de países que amparan las uniones homosexuales
Intermón Oxfam alerta de que las políticas de austeridad podrían retrasar 25 años la recuperación del nivel de vida de 2008
La exconsejera andaluza se queja de que la juez Alaya la impute sin concretar qué delitos le atribuye
El expresidente andaluz denuncia "indefensión" y constata “los efectos políticos aunque no jurídicos” de la acción de Alaya
El Gobierno admite que superará en cuatro décimas el objetivo de déficit este año y rebaja la previsión de crecimiento
El presidente se remite a su versión del 1 de agosto. Rubalcaba pregunta sin éxito sobre el finiquito del extesorero
Goteras provocadas por la rotura de una lona encharcan varios escaños y retrasan la sesión de control
El exdirector del FROB Julián Atienza afirma en las Cortes: "No es que no hicieran caso, sino que hacían todo lo contrario"
Los docentes del sistema público eran hasta ahora los únicos competentes para evaluar la Selectividad
La comunidad judía en España ve un "progreso" en la propuesta, pero pide que se extienda a la historia de su pueblo
El CNIO logra generar por primera vez en un ratón vivo células madre embrionarias. Son de una extraordinaria versatilidad
Demetrio Carceller está imputado por ayudar a su padre a defraudar 72 millones de euros entre 2001 y 2009
Según el juez, tenían “el deber de intervenir” si los responsables de Seguridad no usaban medios para prevenir el error humano
EXPATRIADOS POR LA CRISIS
La primera potencia mundial es aún tierra de oportunidades, pero lograr autorización para trabajar exige preparación
El Gobierno quiere aumentar la casi nula eficacia de las oficinas de empleo vinculando el dinero que reciben a su efectividad
40º ANIVERSARIO DEL GOLPE DE PINOCHET
La expresidenta participó en el acto que se realizó en Villa Grimaldi, centro de detención y tortura del régimen de Pinochet
Una nieta de Salvador Allende recuerda a los miles de chilenos que padecieron el horror de la represión bajo la dictadura
Pietro Parolin reclama que la Iglesia muestre un “espíritu democrático”, en el sentido de “escuchar” a los fieles y al mundo
El ministerio público afirma que la teoría de que el disidente fue asesinado por el régimen castrista queda “desdibujada”
La justicia sentencia que las creencias religiosas no exoneran a las chicas de participar en la clase de natación
- 09:53
- 09:45
- 10:00
- 09:35
- 09:46
El Ejército se suma a las tareas de extinción en Negreira. Un detenido por provocar el gran fuego de 1.800 hectáreas en Oia
"Tenemos la intención de terminar las obras la temporada 2015/16 para entrar en el estadio en la siguiente", asegura el consejero delegado, Gil Marín. El club tendría que haberse trasladado en 2011
El operador utilizará el dinero que obtenga con la operación para financiar la compra a Vodafone
El 'Planetsolar' amarra a la orilla del Sena como colofón de su segunda misión, en la que ha estudiado la regulación del clima